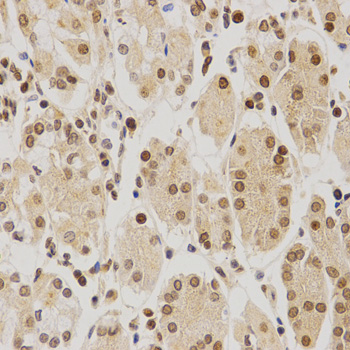

For quotations, please use our online quotation form, and you may also contact us by
service@kendallscientific.com
+1-888.733.6849 (Toll-free)
+1-617.299.7367 (Int’l))
+1-888.733.6849
Our customer service representatives are available 24 hours, Monday through Friday to assist you.| Reactivity | Human Mouse Rat |
| Tested applications | WB IHC IF |
| Recommended Dilution | WB 1:500 - 1:2000 IHC 1:50 - 1:200 IF 1:50 - 1:200 |
| Calculated MW | 37kDa |
| Observed MW | Refer to Figures |
| Immunogen | Recombinant protein of human BMI1 |
| Storage Buffer | Store at -20℃. Avoid freeze / thaw cycles. Buffer: PBS with 0.02% sodium azide, 50% glycerol, pH7.3. |
| Concentration | fl |
| Synonym | BMI1 ; Polycomb complex protein BMI 1; RING finger protein 51; RNF51; PCGF4 |

Western blot analysis of extracts of K562 cells using BMI1 antibody.

Immunohistochemistry of paraffin-embedded human esophageal cancer using BMI1 antibody at dilution of 1:200 (x400 lens).
Immunohistochemistry of paraffin-embedded human stomach using BMI1 antibody at dilution of 1:200 (x400 lens).

Immunohistochemistry of paraffin-embedded mouse brain using BMI1 antibody at dilution of 1:200 (x400 lens).

Immunohistochemistry of paraffin-embedded mouse kidney using BMI1 antibody at dilution of 1:200 (x400 lens).

Immunohistochemistry of paraffin-embedded Human gastric cancer using BMI1 antibody at dilution of 1:100 (x400 lens).

Immunofluorescence analysis of HeLa cell using BMI1 antibody. Blue: DAPI for nuclear staining.
The polycomb group (PcG) of proteins contributes to the maintenance of cell identity, stem cell self-renewal, cell cycle regulation, and oncogenesis by maintaining the silenced state of genes that promote cell lineage specification, cell death, and cell-cycle arrest (1-4). PcG proteins exist in two complexes that cooperate to maintain long-term gene silencing through epigenetic chromatin modifications. The first complex, EED-EZH2, is recruited to genes by DNA-binding transcription factors and methylates histone H3 on Lys27. This histone methyl-transferase activity requires the Ezh2, Eed, and Suz12 subunits of the complex (5). Histone H3 methylation at Lys27 facilitates the recruitment of the second complex, PRC1, which ubiquitinylates histone H2A on Lys119 (6). Bmi1 is a component of the PRC1 complex, which together with Ring1 strongly enhances the E3 ubiquitin ligase activity of the Ring2 catalytic subunit (7). Bmi1 plays an important role in the regulation of cell proliferation and senescence through repression of the p16 INK4A and p19 ARF genes and is required for maintenance of adult hematopoietic and neural stem cells (3,4,8-10).
N/A